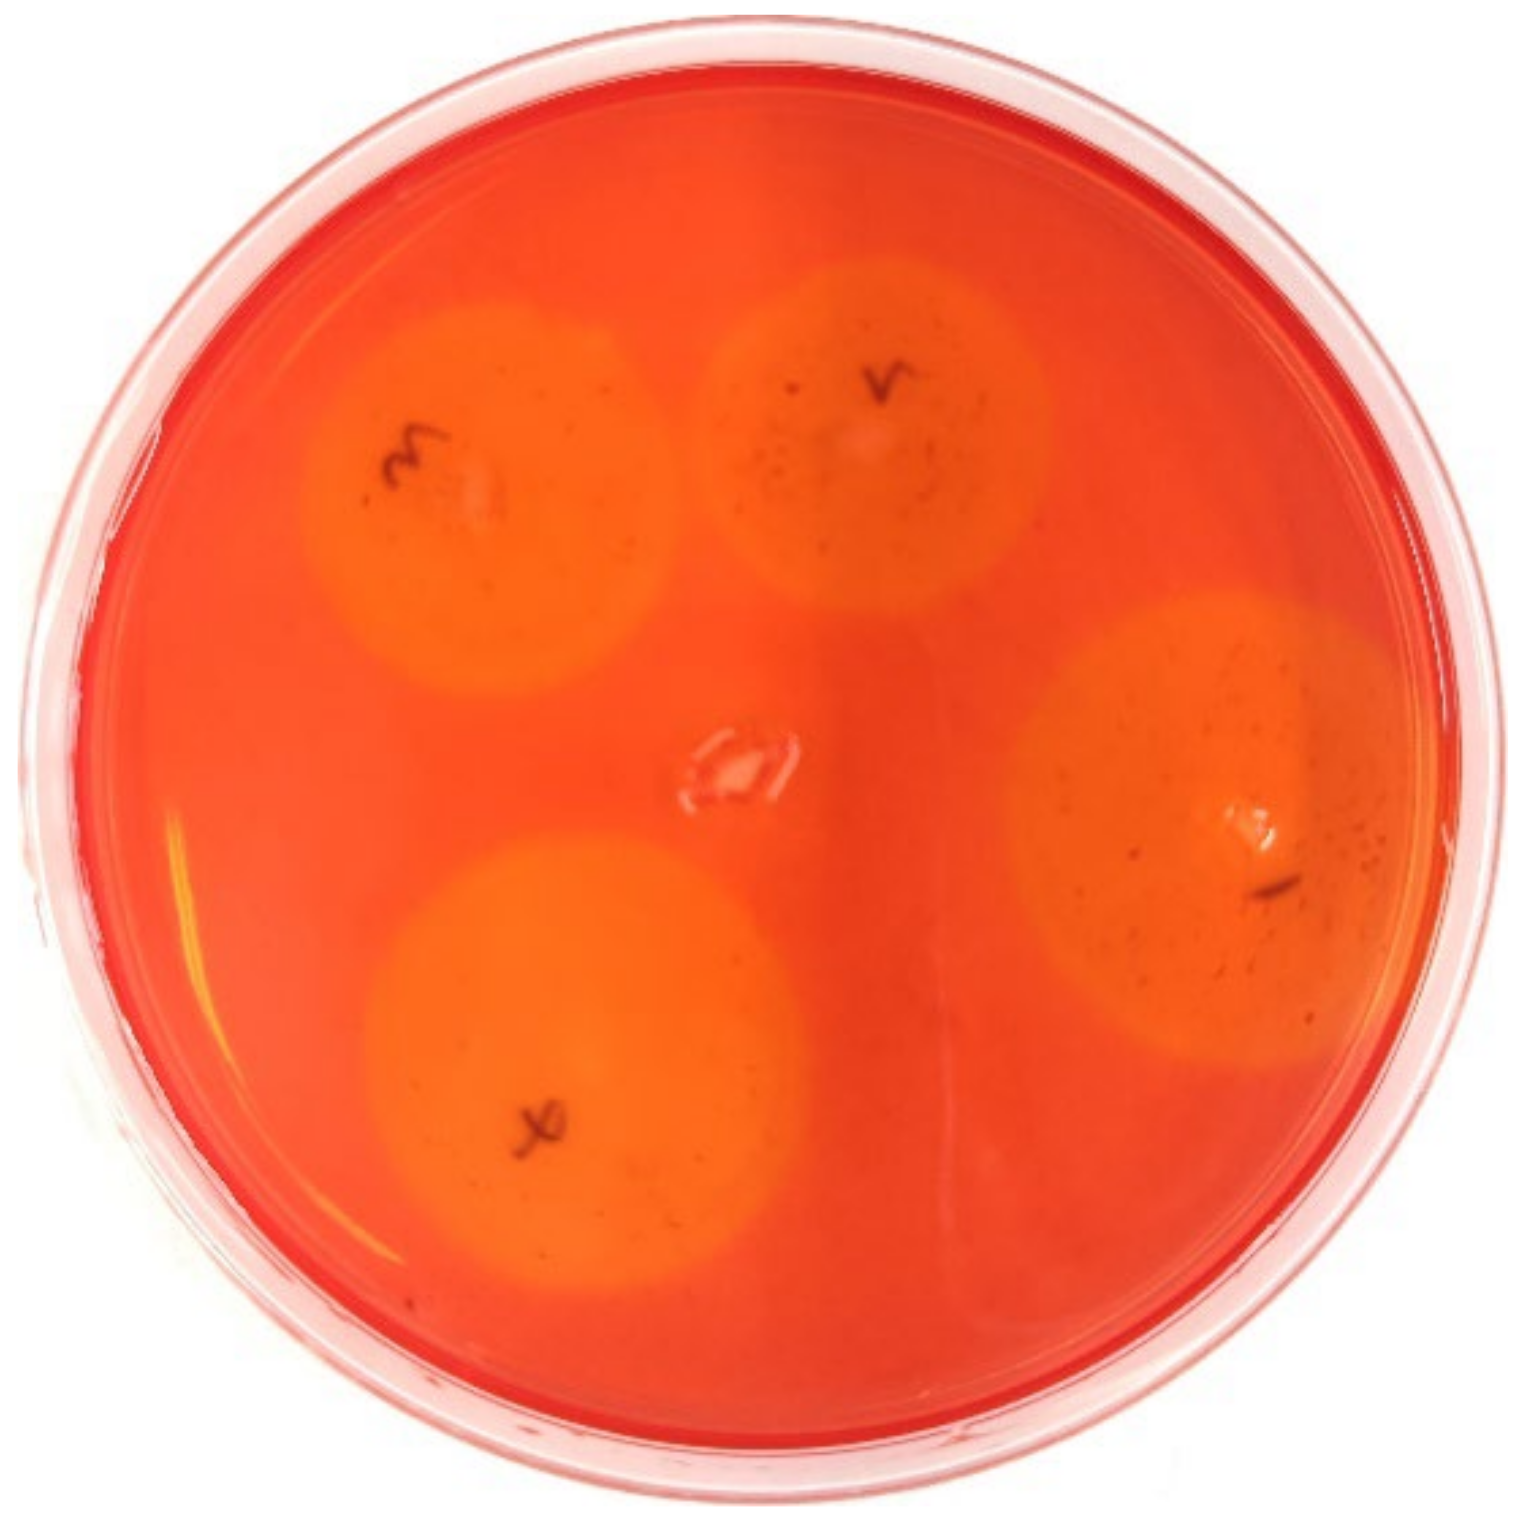
Insects 13 00838 g007 550

Antibiotic Treatment Reduced the Gut Microbiota Diversity, Prolonged the Larval Development Period and Lessened Adult Fecundity of Grapholita molesta (Lepidoptera: Tortricidae)
Abstract
:Simple Summary
Abstract
1. Introduction
2. Materials and Methods
2.1. Insect Reared and Sample Processing
2.2. Screening of Types and Concentrations of Antibiotics
2.3. Antibiotic Treatment
2.4. DNA Extraction, High-Throughput Sequencing, and Bioinformatics Analysis
2.5. Effects of Antibiotic Treatment on the Growth, Development, and Reproduction of G. molesta
2.6. Isolation and Purification of Culturable Bacteria from the G. molesta Midgut
2.7. Bacteria Recolonization
3. Results
3.1. Evaluation of Antimicrobial Effects of the Different Antibiotics
3.2. Screening of the Minimum Inhibitory Concentration
3.3. Effects of Ciprofloxacin on the Gut Microbiota Structure of G. molesta
3.4. Effects of Antibiotic Treatment on the Growth, Development, and Reproduction of G. molesta
3.5. Identification of Culturable Gut Bacteria
3.6. Effects of Cellulase-Producing Bacteria on the Growth and Development of G. molesta Larvae
4. Discussion
5. Conclusions
Author Contributions
Funding
Data Availability Statement
Acknowledgments
Conflicts of Interest
References
- Myers, C.T.; Hull, L.A.; Krawczyk, G. Effects of orchard host plants on the oviposition preference of the oriental fruit moth (Lepidoptera: Tortricidae). J. Econ. Entomol. 2006, 99, 1176–1183. [Google Scholar] [CrossRef] [PubMed]
- Su, S.; Wang, X.; Jian, C.; Ignatus, A.D.; Zhang, X.; Peng, X.; Chen, M. Life-history traits and flight capacity of Grapholita molesta (Lepidoptera: Tortricidae) using artificial diets with varying sugar content. J. Econ. Entomol. 2021, 114, 112–121. [Google Scholar] [CrossRef] [PubMed]
- Zhang, J.; Tang, R.; Fang, H.; Liu, X.; Michaud, J.P.; Zhou, Z.; Zhang, Q.; Li, Z. Laboratory and field studies supporting augmentation biological control of oriental fruit moth, Grapholita molesta (Lepidoptera: Tortricidae), using Trichogramma dendrolimi (Hymenoptera: Trichogrammatidae). Pest Manag. Sci. 2021, 77, 2795–2803. [Google Scholar] [CrossRef] [PubMed]
- Kong, W.N.; Wang, Y.; Guo, Y.F.; Chai, X.H.; Li, J.; Ma, R.Y. Behavioral effects of different attractants on adult male and female oriental fruit moths, Grapholita molesta. Pest Manag. Sci. 2020, 76, 3225–3235. [Google Scholar] [CrossRef] [PubMed]
- Gong, Y.J.; Shi, B.C.; Kang, Z.J.; Zhang, F.; Wei, S.J. The complete mitochondrial genome of the oriental fruit moth Grapholita molesta (Busck) (Lepidoptera: Tortricidae). Mol. Biol. Rep. 2012, 39, 2893–2900. [Google Scholar] [CrossRef]
- Chen, L.H.; Tian, K.; Wang, G.R.; Xu, X.L.; He, K.H.; Liu, W.; Wu, J.X. The general odorant receptor GmolOR9 from Grapholita molesta (Lepidoptera: Tortricidae) is mainly tuned to eight host-plant volatiles. Insect Sci. 2020, 27, 1233–1243. [Google Scholar] [CrossRef]
- Sarker, S.; Woo, Y.H.; Lim, U.T. Laboratory evaluation of Beauveria bassiana ARP14 against Grapholita molesta (Lepidoptera: Tortricidae). Curr. Microbiol. 2020, 77, 2365–2373. [Google Scholar] [CrossRef]
- Najar-Rodriguez, A.; Orschel, B.; Dorn, S. Season-long volatile emissions from peach and pear trees in situ, overlapping profiles, and olfactory attraction of an oligophagous fruit moth in the laboratory. J. Chem. Ecol. 2013, 39, 418–429. [Google Scholar] [CrossRef]
- Kanga, L.H.; Pree, D.J.; van Lier, J.L.; Walker, G.M. Management of insecticide resistance in Oriental fruit moth (Grapholita molesta; Lepidoptera: Tortricidae) populations from Ontario. Pest Manag. Sci. 2003, 59, 921–927. [Google Scholar] [CrossRef]
- Liu, Y.J.; Shen, Z.J.; Yu, J.M.; Li, Z.; Liu, X.X.; Xu, H.L. Comparison of gut bacterial communities and their associations with host diets in four fruit borers. Pest Manag. Sci. 2020, 76, 1353–1362. [Google Scholar] [CrossRef]
- Wang, X.; Sun, S.; Yang, X.; Cheng, J.; Wei, H.; Li, Z.; Michaud, J.P.; Liu, X. Variability of gut microbiota across the life cycle of Grapholita molesta (Lepidoptera: Tortricidae). Front. Microbiol. 2020, 11, 1366. [Google Scholar] [CrossRef] [PubMed]
- Cassone, B.J.; Grove, H.C.; Elebute, O.; Villanueva, S.M.P.; LeMoine, C.M.R. Role of the intestinal microbiome in low-density polyethylene degradation by caterpillar larvae of the greater wax moth, Galleria mellonella. Proc. R. Soc. B 2020, 287, 20200112. [Google Scholar] [CrossRef] [PubMed]
- Dillon, R.J.; Dillon, V.M. The gut bacteria of insects: Nonpathogenic interactions. Annu. Rev. Entomol. 2004, 49, 71–92. [Google Scholar] [CrossRef] [PubMed]
- Voirol, L.R.P.; Frago, E.; Kaltenpoth, M.; Hilker, M.; Fatouros, N.E. Bacterial symbionts in Lepidoptera: Their diversity, transmission, and impact on the host. Front. Microbiol. 2018, 9, 556. [Google Scholar] [CrossRef] [PubMed]
- Ryu, J.H.; Ha, E.M.; Lee, W.J. Innate immunity and gut-microbe mutualism in Drosophila. Dev. Comp. Immunol. 2010, 34, 369–376. [Google Scholar] [CrossRef]
- Ryu, J.H.; Kim, S.H.; Lee, H.Y.; Bai, J.Y.; Nam, Y.D.; Bae, J.W.; Lee, D.G.; Shin, S.C.; Ha, E.M.; Lee, W.J. Innate immune homeostasis by the homeobox gene caudal and commensal-gut mutualism in Drosophila. Science 2008, 319, 777–782. [Google Scholar] [CrossRef]
- Broderick, N.A.; Raffa, K.F.; Handelsman, J. Midgut bacteria required for Bacillus thuringiensis insecticidal activity. Proc. Natl. Acad. Sci. USA 2006, 103, 15196–15199. [Google Scholar] [CrossRef]
- Broderick, N.A.; Robinson, C.J.; McMahon, M.D.; Holt, J.; Handelsman, J.; Raffa, K.F. Contributions of gut bacteria to Bacillus thuringiensis-induced mortality vary across a range of Lepidoptera. BMC Biol. 2009, 7, 11. [Google Scholar] [CrossRef]
- Cai, T.; Zhang, Y.; Liu, Y.; Deng, X.; He, S.; Li, J.; Wan, H. Wolbachia enhances expression of NlCYP4CE1 in Nilaparvata lugens in response to imidacloprid stress. Insect Sci. 2021, 28, 355–362. [Google Scholar] [CrossRef]
- Ben Ami, E.; Yuval, B.; Jurkevitch, E. Manipulation of the microbiota of mass-reared Mediterranean fruit flies Ceratitis capitata (Diptera: Tephritidae) improves sterile male sexual performance. ISME J. 2010, 4, 28–37. [Google Scholar] [CrossRef]
- Engel, P.; Moran, N.A. The gut microbiota of insects—Diversity in structure and function. FEMS Microbiol. Rev. 2013, 37, 699–735. [Google Scholar] [CrossRef] [PubMed]
- Sharon, G.; Segal, D.; Ringo, J.M.; Hefetz, A.; Zilber-Rosenberg, I.; Rosenberg, E. Commensal bacteria play a role in mating preference of Drosophila melanogaster. Proc. Natl. Acad. Sci. USA 2010, 107, 20051–20056. [Google Scholar] [CrossRef] [PubMed]
- Huang, K.; Wang, J.; Huang, J.; Zhang, S.; Vogler, A.P.; Liu, Q.; Li, Y.; Yang, M.; Li, Y.; Zhou, X. Host phylogeny and diet shape gut microbial communities within bamboo-feeding insects. Front. Microbiol. 2021, 12, 633075. [Google Scholar] [CrossRef] [PubMed]
- Zhu, Y.X.; Song, Y.L.; Hoffmann, A.A.; Jin, P.Y.; Huo, S.M.; Hong, X.Y. A change in the bacterial community of spider mites decreases fecundity on multiple host plants. Microbiologyopen 2019, 8, e00743. [Google Scholar] [CrossRef] [PubMed]
- Zhang, X.; Li, T.P.; Zhou, C.Y.; Zhao, D.S.; Zhu, Y.X.; Bing, X.L.; Huang, H.J.; Hong, X.Y. Antibiotic exposure perturbs the bacterial community in the small brown planthopper Laodelphax striatellus. Insect Sci. 2020, 27, 895–907. [Google Scholar] [CrossRef]
- Colman, D.R.; Toolson, E.C.; Takacs-Vesbach, C.D. Do diet and taxonomy influence insect gut bacterial communities? Mol. Ecol. 2012, 21, 5124–5137. [Google Scholar] [CrossRef]
- Johnston, P.R.; Rolff, J. Host and symbiont jointly control gut microbiota during complete metamorphosis. PLoS Pathog. 2015, 11, e1005246. [Google Scholar] [CrossRef]
- Erkosar, B.; Yashiro, E.; Zajitschek, F.; Friberg, U.; Maklakov, A.A.; van der Meer, J.R.; Kawecki, T.J. Host diet mediates a negative relationship between abundance and diversity of Drosophila gut microbiota. Ecol. Evol. 2018, 8, 9491–9502. [Google Scholar] [CrossRef]
- Kudo, R.; Masuya, H.; Endoh, R.; Kikuchi, T.; Ikeda, H. Gut bacterial and fungal communities in ground-dwelling beetles are associated with host food habit and habitat. ISME J. 2019, 13, 676–685. [Google Scholar] [CrossRef]
- Gong, Q.; Cao, L.J.; Sun, L.N.; Chen, J.C.; Gong, Y.J.; Pu, D.Q.; Huang, Q.; Hoffmann, A.A.; Wei, S.J. Similar gut bacterial microbiota in two fruit-feeding moth pests collected from different host species and locations. Insects 2020, 11, 840. [Google Scholar] [CrossRef]
- Lee, J.B.; Park, K.E.; Lee, S.A.; Jang, S.H.; Eo, H.J.; Jang, H.A.; Kim, C.H.; Ohbayashi, T.; Matsuura, Y.; Kikuchi, Y.; et al. Gut symbiotic bacteria stimulate insect growth and egg production by modulating hexamerin and vitellogenin gene expression. Dev. Comp. Immunol. 2017, 69, 12–22. [Google Scholar] [CrossRef] [PubMed]
- Zhang, Y.; Zhao, T.; Deng, J.; Zhou, X.; Wu, Z.; Su, Q.; Zhang, L.; Long, Y.; Yang, Y. Positive effects of the tea catechin (-)-epigallocatechin-3-gallate on gut bacteria and fitness of Ectropis obliqua Prout (Lepidoptera: Geometridae). Sci. Rep. 2019, 9, 5021. [Google Scholar] [CrossRef] [PubMed]
- Chen, B.; Zhang, N.; Xie, S.; Zhang, X.; He, J.; Muhammad, A.; Sun, C.; Lu, X.; Shao, Y. Gut bacteria of the silkworm Bombyx mori facilitate host resistance against the toxic effects of organophosphate insecticides. Environ. Int. 2020, 143, 105886. [Google Scholar] [CrossRef] [PubMed]
- Li, Y.; Schal, C.; Pan, X.; Huang, Y.; Zhang, F. Effects of antibiotics on the dynamic balance of bacteria and fungi in the gut of the German Cockroach. J. Econ. Entomol. 2020, 113, 2666–2678. [Google Scholar] [CrossRef] [PubMed]
- Mohlmann, T.W.R.; Vogels, C.B.F.; Goertz, G.P.; Pijlman, G.P.; Ter Braak, C.J.F.; Te Beest, D.E.; Hendriks, M.; Nijhuis, E.H.; Warris, S.; Drolet, B.S.; et al. Impact of gut bacteria on the Infection and transmission of pathogenic arboviruses by biting midges and mosquitoes. Microb. Ecol. 2020, 80, 703–717. [Google Scholar] [CrossRef]
- Noman, M.S.; Shi, G.; Liu, L.J.; Li, Z.H. Diversity of bacteria in different life stages and their impact on the development and reproduction of Zeugodacus tau (Diptera: Tephritidae). Insect Sci. 2021, 28, 363–376. [Google Scholar] [CrossRef]
- Yuan, X.; Zhang, X.; Liu, X.; Dong, Y.; Yan, Z.; Lv, D.; Wang, P.; Li, Y. Comparison of gut bacterial communities of Grapholita molesta (Lepidoptera: Tortricidae) reared on different host plants. Int. J. Mol. Sci. 2021, 22, 6843. [Google Scholar] [CrossRef]
- Clinical and Laboratory Standards Institute. Methods for dilution antimicrobial susceptibility tests for bacteria that grow aerobically; Approved Standard. In CLSI Document M07-A9, 7th ed.; Clinical and Laboratory Standards Institute: Wayne, PA, USA, 2012. [Google Scholar]
- Visweshwar, R.; Sharma, H.C.; Akbar, S.M.; Sreeramulu, K. Elimination of gut microbes with sntibiotics confers resistance to Bacillus thuringiensis toxin proteins in Helicoverpa armigera (Hubner). Appl. Biochem. Biotechnol. 2015, 177, 1621–1637. [Google Scholar] [CrossRef]
- Bai, Z.; Liu, L.; Noman, M.S.; Zeng, L.; Luo, M.; Li, Z. The influence of antibiotics on gut bacteria diversity associated with laboratory-reared Bactrocera dorsalis. Bull. Entomol. Res. 2019, 109, 500–509. [Google Scholar] [CrossRef]
- Visotto, L.E.; Oliveira, M.G.; Guedes, R.N.; Ribon, A.O.; Good-God, P.I. Contribution of gut bacteria to digestion and development of the velvetbean caterpillar, Anticarsia gemmatalis. J. Insect Physiol. 2009, 55, 185–191. [Google Scholar] [CrossRef]
- Kafil, M.; Bandani, A.R.; Kaltenpoth, M.; Goldansaz, S.H.; Alavi, S.M. Role of symbiotic bacteria in the growth and development of the Sunn pest, Eurygaster integriceps. J. Insect Sci. 2013, 13, 99. [Google Scholar] [CrossRef] [PubMed]
- Storelli, G.; Defaye, A.; Erkosar, B.; Hols, P.; Royet, J.; Leulier, F. Lactobacillus plantarum promotes Drosophila systemic growth by modulating hormonal signals through TOR-dependent nutrient sensing. Cell Metab. 2011, 14, 403–414. [Google Scholar] [CrossRef] [PubMed]
- Israni, B.; Rajam, M.V. Silencing of ecdysone receptor, insect intestinal mucin and sericotropin genes by bacterially produced double-stranded RNA affects larval growth and development in Plutella xylostella and Helicoverpa armigera. Insect Mol. Biol. 2017, 26, 164–180. [Google Scholar] [CrossRef]
- Valzania, L.; Martinson, V.G.; Harrison, R.E.; Boyd, B.M.; Cooncurrency, K.L.; Brown, M.R.; Strand, M.R. Both living bacteria and eukaryotes in the mosquito gut promote growth of larvae. PLoS Negl. Trop. Dis. 2018, 12, e0006638. [Google Scholar] [CrossRef] [PubMed]
- Valzania, L.; Coon, K.L.; Vogel, K.J.; Brown, M.R.; Strand, M.R. Hypoxia-induced transcription factor signaling is essential for larval growth of the mosquito Aedes aegypti. Proc. Natl. Acad. Sci. USA 2018, 115, 457–465. [Google Scholar] [CrossRef]
- Westfall, S.; Lomis, N.; Prakash, S. Ferulic acid produced by Lactobacillus fermentum influences developmental growth through a dTOR-mediated mechanism. Mol. Biotechnol. 2019, 61, 1–11. [Google Scholar] [CrossRef]
- Consuegra, J.; Grenier, T.; Baa-Puyoulet, P.; Rahioui, I.; Akherraz, H.; Gervais, H.; Parisot, N.; da Silva, P.; Charles, H.; Calevro, F.; et al. Drosophila-associated bacteria differentially shape the nutritional requirements of their host during juvenile growth. PLoS Biol. 2020, 18, e3000681. [Google Scholar] [CrossRef]
- Wang, Y.; Zhu, J.Q.; Fang, J.; Shen, L.; Ma, S.J.; Zhao, Z.M.; Yu, W.D.; Jiang, W.B. Diversity, composition and functional inference of gut microbiota in indian cabbage white Pieris canidia (Lepidoptera: Pieridae). Life 2020, 10, 254. [Google Scholar] [CrossRef]
- Jose, P.A.; Ben-Yosef, M.; Jurkevitch, E.; Yuval, B. Symbiotic bacteria affect oviposition behavior in the olive fruit fly Bactrocera oleae. J. Insect Physiol. 2019, 117, 103917. [Google Scholar] [CrossRef]
- Akami, M.; Ren, X.M.; Qi, X.; Mansour, A.; Gao, B.; Cao, S.; Niu, C.Y. Symbiotic bacteria motivate the foraging decision and promote fecundity and survival of Bactrocera dorsalis (Diptera: Tephritidae). BMC Microbiol. 2019, 19, 229. [Google Scholar] [CrossRef] [Green Version]
- Liu, W.; Wang, J.; Zhang, H.Y.; Yang, Y.C.; Kang, R.X.; Bai, P.; Fu, H.; Chen, L.R.; Gao, Y.P.; Tan, E.K. Symbiotic bacteria attenuate Drosophila oviposition repellence to alkaline through acidification. Insect Sci. 2021, 28, 403–414. [Google Scholar] [CrossRef] [PubMed]
- Tian, B.; Fadhil, N.H.; Powell, J.E.; Kwong, W.K.; Moran, N.A.J.M. Long-term exposure to antibiotics has caused accumulation of resistance determinants in the gut microbiota of honeybees. mBio 2012, 3, e00377-12. [Google Scholar] [CrossRef] [PubMed]
- Shatalin, K.; Nuthanakanti, A.; Kaushik, A.; Shishov, D.; Peselis, A.; Shamovsky, I.; Pani, B.; Lechpammer, M.; Vasilyev, N.; Shatalina, E.; et al. Inhibitors of bacterial H2S biogenesis targeting antibiotic resistance and tolerance. Science 2021, 372, 1169–1175. [Google Scholar] [CrossRef] [PubMed]

| Antibiotic | Content/μg | Diameter of Bacteriostatic Zone/mm | Criteria for Determination of Bacteriostatic Effect/mm | Result | ||
|---|---|---|---|---|---|---|
| Resistant | Moderate | Sensitive | ||||
| Ciprofloxacin | 5 | 37.7 ± 0.6 a | ≤15 | 16–20 | ≥21 | Sensitive |
| Streptomycin | 10 | 23.3 ± 2.1 b | ≤11 | 12–14 | ≥15 | Sensitive |
| Chloramphenicol | 30 | 16.0 ± 1.5 c | ≤12 | 13–17 | ≥18 | Moderate |
| Rifampicin | 5 | 0 ± 0.0 d | ≤16 | 17–19 | ≥20 | Resistant |
| Ampicillin | 10 | 0 ± 0.0 d | ≤13 | 14–16 | ≥17 | Resistant |
| Sample ID | Raw Reads | Clean Reads | Effective Reads | AvgLen (bp) | GC(%) | Q20(%) | Q30(%) | Effective (%) |
|---|---|---|---|---|---|---|---|---|
| CK1 | 80,066 | 79,771 | 76,755 | 417 | 53.50 | 99.20 | 96.67 | 95.86 |
| CK2 | 80,265 | 80,017 | 76,925 | 417 | 54.61 | 99.20 | 96.68 | 95.84 |
| CK3 | 79,983 | 79,662 | 76,948 | 417 | 54.09 | 99.17 | 96.57 | 96.21 |
| T1 | 80,452 | 80,209 | 77,087 | 417 | 53.83 | 99.15 | 96.52 | 95.82 |
| T2 | 79,820 | 79,536 | 76,753 | 419 | 52.79 | 99.14 | 96.45 | 96.16 |
| T3 | 79,882 | 79,596 | 77,027 | 417 | 52.25 | 99.15 | 96.50 | 96.43 |
| Sample ID | ACE | Chao 1 | Shannon | Simpson | Coverage |
|---|---|---|---|---|---|
| CK | 1269.3823 ± 156.1559 a | 1301.3513 ± 147.2708 a | 8.3728 ± 0.4138 a | 0.9859 ± 0.0073 a | 0.9986 ± 0.0003 a |
| T | 1091.6186 ± 98.2405 a | 1150.1026 ± 104.2863 a | 7.3237 ± 0.5705 a | 0.9740 ± 0.0081 a | 0.9985 ± 0.0001 a |
| Group | Firmicutes | Bacteroidetes | Proteobacteria | Actinobacteriota | Cyanobacteria | Acidobacteriota | Verrucomicrobiota | Fusobacteriota | Desulfobacterota | Campilobacterota |
|---|---|---|---|---|---|---|---|---|---|---|
| CK | 27.40 ± 4.99 a | 15.33 ± 1.64 a | 20.17 ± 2.07 a | 5.20 ± 0.48 a | 9.68 ± 0.19 a | 3.38 ± 1.24 a | 2.21 ± 0.49 a | 1.13 ± 0.38 a | 0.82 ± 0.11 a | 0.64 ± 0.10 a |
| T | 39.56 ± 3.15 a | 23.67 ± 2.54 a | 14.89 ± 1.89 a | 2.42 ± 0.38 b | 0.07 ± 0.03 b | 2.19 ± 0.95 a | 1.21 ± 0.73 a | 1.72 ± 1.19 a | 0.97 ± 0.22 a | 0.31 ± 0.12 a |
| Group | Larval Duration | Pupal Duration | Adult Longevity | Larval-Adult Total Duration |
|---|---|---|---|---|
| CK | 13.54 ± 0.04 b | 7.11 ± 0.12 a | 17.86 ± 0.16 a | 38.11 ± 0.06 a |
| T | 14.47 ± 0.20 a | 7.24 ± 0.03 a | 16.68 ± 0.36 b | 38.11 ± 0.92 a |
| Group | CK | T |
|---|---|---|
| Larval survival rate/% | 50.67 ± 1.45 a | 48.33 ± 2.03 a |
| Pupation rate/% | 94.13 ± 0.98 a | 92.34 ± 2.00 a |
| Pupal weight/mg | 10.78 ± 0.27 a | 10.55 ± 0.22 a |
| Emergence rate/% | 87.38 ± 2.46 a | 86.49 ± 0.76 a |
| No. eggs per female | 122.13 ± 4.96 a | 87.54 ± 5.72 b |
| Egg hatchability/% | 80.20 ± 3.30 a | 58.24 ± 6.69 b |
| Group | Clone No. | Origin Strain of Blasted Sequences with the Highest Identity | Phylum | GenBank Accession No. | Identity (%) |
|---|---|---|---|---|---|
| CK | CK1 | Staphylococcus warneri | Firmicutes | MH910124.1 | 100 |
| CK2 | Micrococcus sp. | Actinobacteria | LC484692.1 | 99.93 | |
| CK3 | Microbacterium imperiale | Actinobacteria | JN585685.1 | 100 | |
| CK4 | Microbacterium arborescens | Actinobacteria | MN198184.1 | 100 | |
| CK5 | Staphylococcus sp. | Firmicutes | MK757916.1 | 99.86 | |
| CK6 | Staphylococcus epidermidis | Firmicutes | MW391759.1 | 99.93 | |
| CK7 | Staphylococcus hominis subsp. hominis | Firmicutes | KX510094.1 | 99.93 | |
| CK8 | Staphylococcus hominis | Firmicutes | MW391758.1 | 99.93 | |
| CK9 | Staphylococcus hominis subsp. novobiosepticus | Firmicutes | MT544719.1 | 99.86 | |
| CK10 | Microbacterium oxydans | Actinobacteria | KF358264.1 | 100 | |
| T | T1 | Pantoea septica | Proteobacteria | ON197340.1 | 99.44 |
| T2 | Kitasatospora sp. strain C15 | Actinobacteria | MG461679.1 | 99.58 | |
| T3 | Niallia circulans strain S1 | Firmicutes | MK100762.1 | 99.93 | |
| T4 | Staphylococcus hominis subsp. novobiosepticus strain 4149 | Firmicutes | MT544719.1 | 99.93 | |
| T5 | Pantoea sp. strain GIg21 | Proteobacteria | MK312599.1 | 100 |
| Group | CK | T |
|---|---|---|
| BC | 13.93 ± 0.13 b | 7.68 ± 0.03 b |
| CK | 14.86 ± 0.12 a | 8.62 ± 0.04 a |
| Sphingobacterium species | 14.66 ± 0.10 a | 8.49 ± 0.09 a |
| Stenotrophomonas species | 14.86 ± 0.13 a | 8.45 ± 0.16 a |
| uncultured Sphingobacterium | 14.80 ± 0.09 a | 8.54 ± 0.10 a |
Publisher’s Note: MDPI stays neutral with regard to jurisdictional claims in published maps and institutional affiliations. |
© 2022 by the authors. Licensee MDPI, Basel, Switzerland. This article is an open access article distributed under the terms and conditions of the Creative Commons Attribution (CC BY) license (https://creativecommons.org/licenses/by/4.0/).
Share and Cite
Zhang, X.; Wang, X.; Guo, Z.; Liu, X.; Wang, P.; Yuan, X.; Li, Y. Antibiotic Treatment Reduced the Gut Microbiota Diversity, Prolonged the Larval Development Period and Lessened Adult Fecundity of Grapholita molesta (Lepidoptera: Tortricidae). Insects 2022, 13, 838. https://doi.org/10.3390/insects13090838
Zhang X, Wang X, Guo Z, Liu X, Wang P, Yuan X, Li Y. Antibiotic Treatment Reduced the Gut Microbiota Diversity, Prolonged the Larval Development Period and Lessened Adult Fecundity of Grapholita molesta (Lepidoptera: Tortricidae). Insects. 2022; 13(9):838. https://doi.org/10.3390/insects13090838
Chicago/Turabian StyleZhang, Xuan, Xing Wang, Zikun Guo, Xueying Liu, Ping Wang, Xiangqun Yuan, and Yiping Li. 2022. "Antibiotic Treatment Reduced the Gut Microbiota Diversity, Prolonged the Larval Development Period and Lessened Adult Fecundity of Grapholita molesta (Lepidoptera: Tortricidae)" Insects 13, no. 9: 838. https://doi.org/10.3390/insects13090838
APA StyleZhang, X., Wang, X., Guo, Z., Liu, X., Wang, P., Yuan, X., & Li, Y. (2022). Antibiotic Treatment Reduced the Gut Microbiota Diversity, Prolonged the Larval Development Period and Lessened Adult Fecundity of Grapholita molesta (Lepidoptera: Tortricidae). Insects, 13(9), 838. https://doi.org/10.3390/insects13090838

